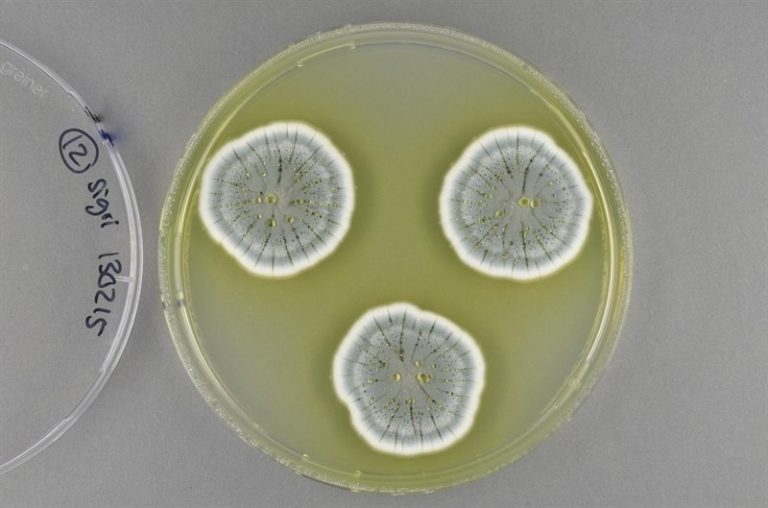

Una mejor alimentación, uso de medicina tradicional para afecciones comunes y el evitar el sobreconsumo de fármacos,...
Mes: abril 2017
El sexto encuentro de STAMP analiza las claves sobre uso de fármacos fuera de indicación en la...
Por Miguel Jara Hay nuevo escándalo sanitario a la vista con los daños a la salud femenina...
No hay riesgo de administrarla en fases tempranas Durante años, por ser un tema tabú, los médicos...
Por © EFE El laboratorio privado EMS, mayor empresa farmacéutica de Brasil, se comprometió a donar todas...
Por el Dr. Mercola A menudo, el estrés comienza con una preocupación o miedo, pero esos sentimientos...
Siliq competirá con una serie de inhibidores de IL-17 existentes, incluyendo Cosentyx de Novartis AG y Taltz...
Era también la medicina de prescripción más cara de la historia y fue utilizada solo por una...
Por: JENS CHRISTIAN NIELSEN MADRID, 21 Abr. (EUROPA PRESS) – Investigadores de la Universidad de Chalmers...
Hasta 4.100 niños en Francia han nacido con malformaciones después de que sus madres tomaran los fármacos...